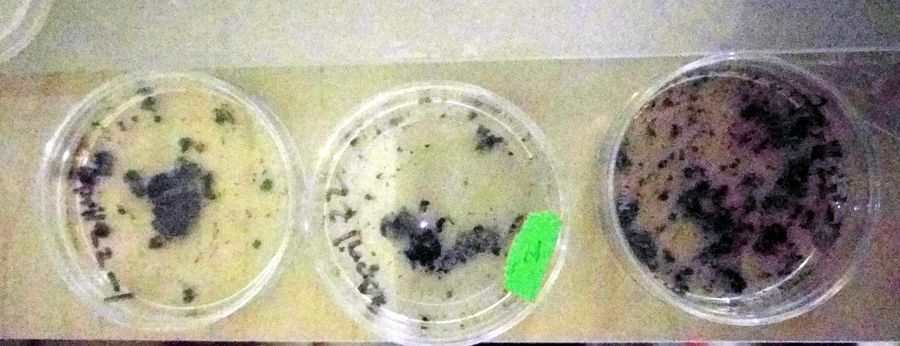

Day 7: Lichen cultures
 May 05, 2017 • 9:42 AM UTC
May 05, 2017 • 9:42 AM UTC Unknown Location
Unknown Location 140x Magnification
140x Magnification Microorganisms
Microorganisms
Laks Iyer
Human observer of life. https://sukshmadarshin.wordpress.com
97posts
1255comments
5locations

View in Media Gallery
Continuing from my previous post, I am going to try and keep an eye on the succession of life in my lichen cultures. For this, I have 6 different lichens collected from different trees put into petridishes containing RO water. Below, I categorize all life I could see after 1 week.
Here are results from three of the plates. Dont miss out the third one. It is full of exciting life that I havent seen before.
Here are results from three of the plates. Dont miss out the third one. It is full of exciting life that I havent seen before.
View in Media Gallery
Plate-number Observation date Species observed April-22-Plate1 April-29-2017 Long-ciliate, Colpoda, liitle Ciliate April-22-Plate2 April-29-2017 Nematode, Large Bdelloid Rotifer, Tardigrade, Long ciliate, Ciliate-24621-2-LI, little ciliate April-22-Plate3 April-29-2017 Nematode, Bdelloid Rotifer, Tardigrade, Amoeba, flagellate, Ciliate-24621-2-LI, flagellate, Ciliate with a terminal contractile vacuole, Colpoda April-21-Plate1 April-29-2017 Nematode, Bdelloid Rotifer, Long ciliate, Stylonychia-like ciliate April-21-Plate2 April-29-2017 Bdelloid Rotifer, Colpoda, Long ciliate April-21-Plate3 April-29-2017 Nematode, Rotifer, Colpoda 1. April-22-Plate 1, Colpoda is the most common ciliate I have seen in over 20 lichen suspension cultures ( see previous observation, this is a different species). It definitely is significantly associated with lichens. Its also very easy to grow. You can culture it in hay infusion. I have done it several times now.
2. April 22-Plate 2. This ciliate (Ciliate-24621-2-LI) is definitely a hypotrich ciliate (reminds me of Ciliate-21501-2-LI). I suspect it is related to Stylonychia . Would you be able to help identify it?.
3. April22-Plate 3. It is amazing how much life is there in this plate…. I thought I’d put it in this post, but I’ll leave it in suspense until the next post 🙂 — To be continued.
This post is open to read and review on The Winnower.
This post is open to read and review on The Winnower.
Sign in to commentNobody has commented yet... Share your thoughts with the author and start the discussion!

 0 Applause
0 Applause 0 Comments
0 Comments_300x300.jpeg)

















